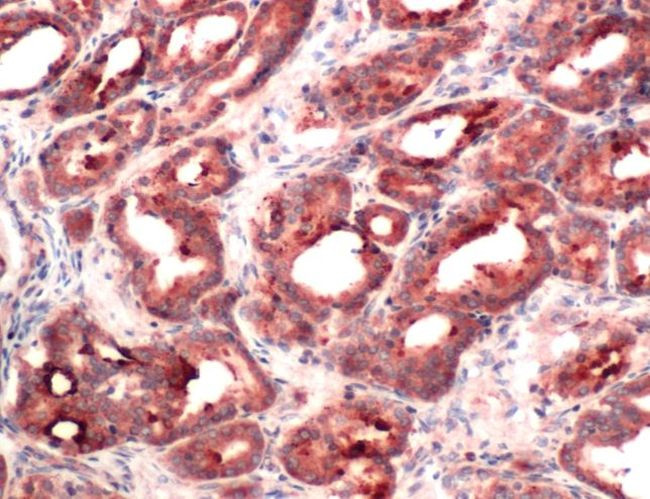
RACK1 Antibody in Immunohistochemistry (IHC)

Search
Invitrogen
RACK1 Polyclonal Antibody
{{$productOrderCtrl.translations['antibody.pdp.commerceCard.promotion.promotions']}}
{{$productOrderCtrl.translations['antibody.pdp.commerceCard.promotion.viewpromo']}}
{{$productOrderCtrl.translations['antibody.pdp.commerceCard.promotion.promocode']}}: {{promo.promoCode}} {{promo.promoTitle}} {{promo.promoDescription}}. {{$productOrderCtrl.translations['antibody.pdp.commerceCard.promotion.learnmore']}}
产品信息
PA5-32569
宿主/亚型
分类
类型
抗原
偶联物
形式
保存条件
运输条件
RRID
产品详细信息
Heat-mediated antigen retrieval is recommended prior to staining, using a 10mM citrate buffer, pH 6.0, for 10 minutes followed by cooling at room temperature for 20 min. Following antigen retrieval, incubate samples with primary antibody for 30 min at room temperature. A suggested positive control is prostate carcinoma.
靶标信息
RACK1 (receptor for activated C kinase 1) was identified through its binding to various PKC isoforms. Its main function is to recruit PKC and various other proteins to specific locations to form multiprotein complexes, mediating various signal pathways. RACK1 is required for VANGL2 membrane localization and for PTK2/FAK1 phosphorylation and dephosphorylation.
仅用于科研。不用于诊断过程。未经明确授权不得转售。